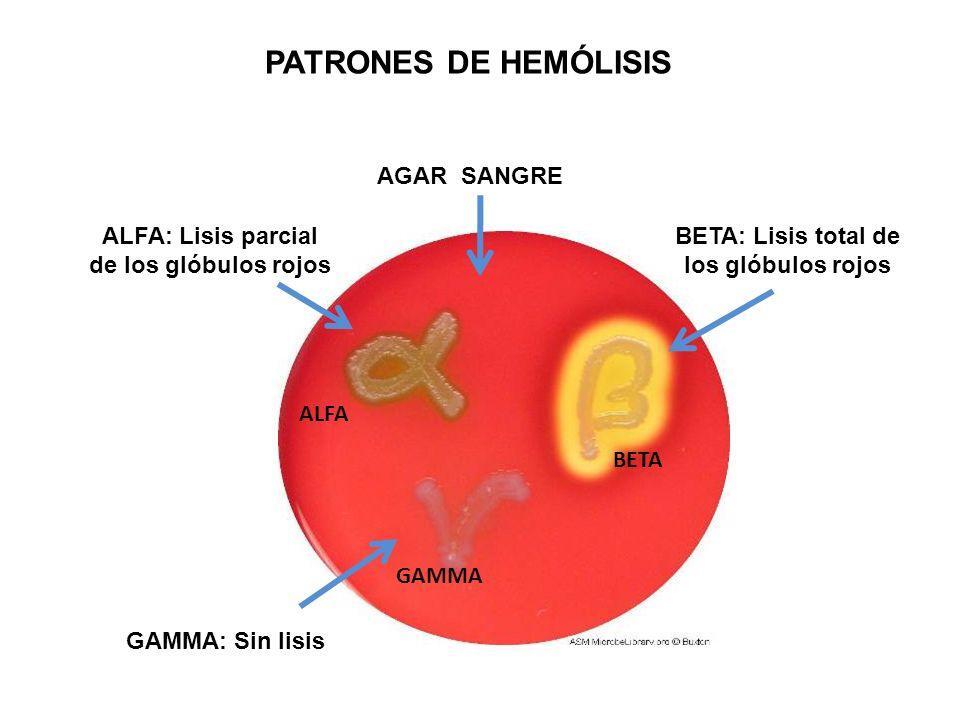

Clasificación de streptococcus
alpha, beta y gamma hemoliticos
Alfa hemolisis
- punto intermedio, hemolisis incompleta
- coloración verdosa

Beta hemolisis
- hemolisis completa e intensa
- muy hábil para destruir eritrocitos
- halo transparente
Gamma hemolisis
- No produce ningún cambio.
- Es incapaz de destruir a los eritrocitos.

Cuál es la hemolisis más compleja ?
Beta hemolisis
Según clasificación fenotípica (A, B y D)
A → S. pyogenes
B → S. agalactiae
D → E. faecium y E. faecalis
Sensible
Optoquina: S. Pneumoniae
Bacitracina: S. Pyogenes
Resistente
Optoquina: S. Viridans
Bacitracina: S. Agalactie
Características microbiológicas Streptococcus
- cocos grampositivos
- pares (diplococos) o cadenas
- anaerobios facultativos
- catalasa negativo (PUNTO DE DIFERENCIACIÓN CON STAPHYLOCOCCUS)
Streptococcus pyogenes
(grupo A)
- cadenas cortas (4-6) (rara vez están en parejas)
- beta hemolisis en agar sangre
- antígeno A en la pared celular
- proteína M
- cepas encapsuladas: inf. sistémicas/graves

Característica particular de S. pyogenes?
Proteína M!!!!!
- Es una proteía estructural asociada a virulencia.
- Ubicada en las fimbrias
- Atraviesa completamente la pared y se proyecta al exterior de la célula.

Mecanismos de patogenicidad S. pyogenes
- Proteinas mediadoras de adhesion:
- Proteína M (UBICADA EN LAS FIMBRIAS)
- Invasinas - capacidad citotoxica
- Enzimas que destruyen moléculas humanas
Evasión de la respuesta inmune S. pyogenes
- Cápsula de ac. hialurónico
- Proteína M: evita fagocitosis
- Peptidasa de C5a: evita quimiotaxis de fagocitos
- Proteína M y F: adherencia e invasión de epitelios
Toxinas S. pyogenes
Spe: exotoxinas pirógenas estreptocócicas: SpeA, SpeB, SpeC, SpeF
- Son superantígenos de la misma familia que las toxinas estafilocócicas
Invasinas S. pyogenes
Enzimas secretadas que destruyen tejidos!!!
- Estreptolisina S → hemolisina no inmune. (hemolisina NO es exclusivo) Produce la beta-hemólisis (destruye eritrocitos)
- Estreptolisina O → inmune; puede detectar anticuerpos (excepto inf. cutáneas)
- Estreptocinasas: lisan/disuelven coágulos de sangre y fibrina (ej. medicamento para trombosis= Fibrinolytic)
- ADNasas: reduce viscosidad de los abscesos
faringitis estreptocócica (grupo A)

- producción de pus en las amígdalas
- destrucción de tejido y mucosa = causada por invasinas
- complicaciones → abcesos retrofaríngeos, parafaringeos, paravertebrales
Faringitis resuelta (lideada por exotoxinas liberadas) ; qué secuelas puede ocasionar ?
- Escarlatina
- Lengua en fresa
- Líneas de pastia

Escarlatina

- erupción cutánea distintiva de color rojo que se extiende por gran parte del cuerpo
- más frecuente en niños
- se liberan a la circulación exotoxinas
- triángulo de Filatov (triángulo/zona preservada de la piel)

Lengua en fresa

- lengua roja con pequeñas protuberancias que se asemejan a las semillas de una fresa
Líneas de pastia

- son líneas rojas en los pliegues de la piel, como los de las axilas, la ingle, el cuello, detrás de las rodillas y en el pliegue del codo
Fiebre reumática
- Criterios de Jones
- Antígenos M1, M3, M5, M6 y M18
- Asociada a infecciones faríngeas, pero NO a cutáneas
Síndrome nefrítico
- infección estreptocócica de la garganta o la piel (faringitis estreptocócica o impétigo)
- edema y P.A. elevada
Erisipela

- streptococcus pyogenesis
- Afecta a la epidermis y dermis superficial
- Los bordes están perfectamente delimitados
- Es un rojo INTENSO
- Es mas frecuente en adultos mayores
Pioderma gangrenoso

- muerte de los tejidos cutáneos y puede ser una fascitis necrotizante (cuando la inf. que estaba en la piel atraviesa las fascias)
- UN CLARO EJEMPLO DE LO FUERTE QUE SON LAS INVASINAS!!!!





